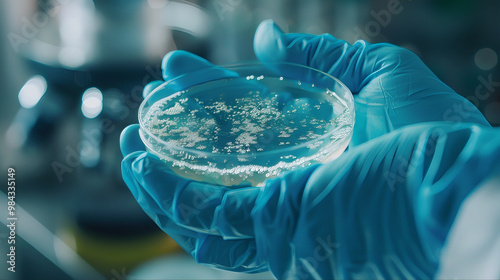

Download sample
File Details
Published: 2024-09-20 14:06:37.154409 Category: Science Type: Illustration Model release: NoShare
Scientist working in laboratory on a research. Hand holding a petri dish for laboratory cultured fungi, bacteria and virus cells scientific research experiment program
Contributor: Taiwo
ID : 984335149
